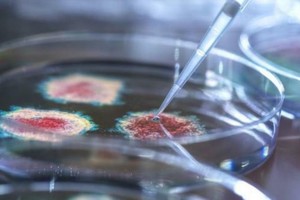
Gentileza
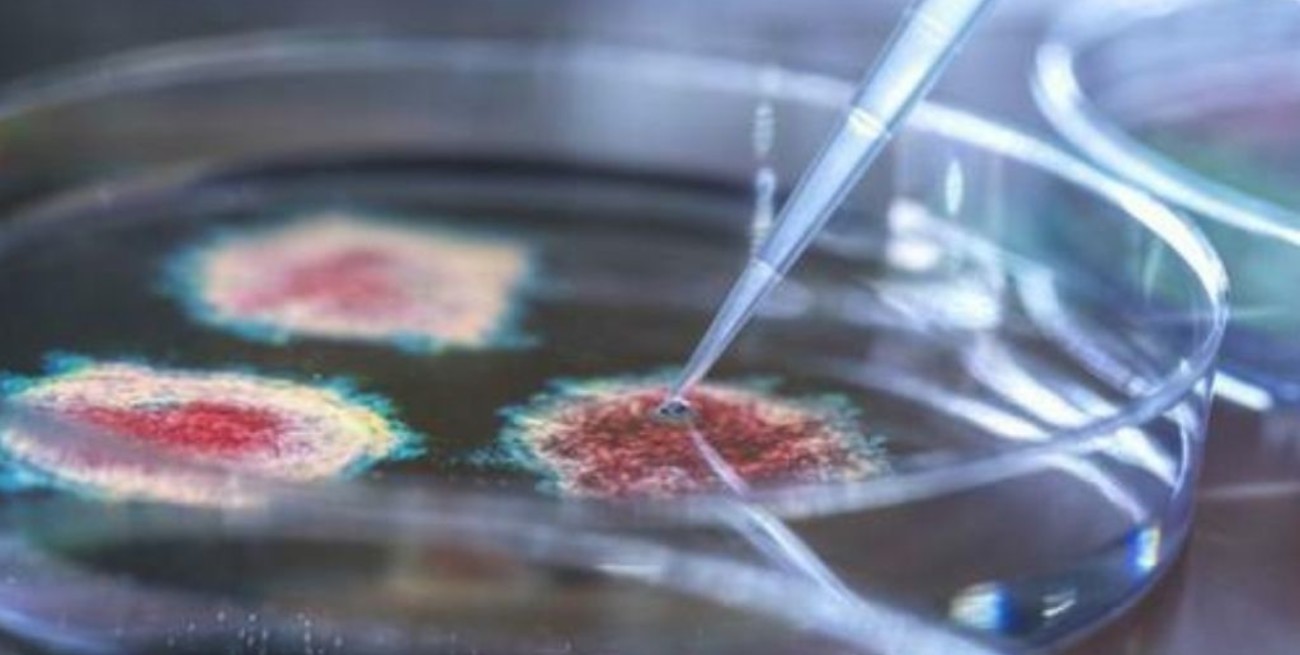

Una pregunta que inquieta con vistas al futuro, teniendo en cuenta las experiencias con Delta es si pueden seguir apareciendo nuevas variantes del coronavirus, pese al avance de la vacunación y la disminución de casos a nivel global. Un temor basado en un posible aumento de letalidad o contagiosidad.
Seguirán apareciendo nuevas variantes del coronavirus
Siempre que haya infecciones, el virus podría seguir mutando y volverse más contagioso o incluso más letal.
La respuesta, aunque compleja, es que sí, siempre y cuando el virus que provocó la pandemia siga infectando a gente. Pero eso no significa que las nuevas variantes vayan a aparecer con tanta frecuencia ni que sean más peligrosas.
Con más de la mitad de la población mundial todavía sin vacunar, es probable que el virus siga encontrando gente a la que infectar y donde seguir replicándose en los próximos meses o años. Y cada vez que esto ocurre podría producirse una pequeña mutación. Estos cambios pueden ayudarle a sobrevivir, convirtiéndose en nuevas variantes.

Pero esto no supone que el virus vaya a seguir evolucionando de la misma forma en que lo ha hecho desde su aparición a finales de 2019.
Cuando un virus infecta a una nueva especie, necesita adaptarse al nuevo receptor para propagarse más ampliamente, dijo Andrew Read, experto en virus de la Universidad Estatal de Pensilvania.
Según los Centros para el Control y Prevención de Enfermedades (CDC, por sus siglas en inglés), la variante delta es dos veces más contagiosa que las versiones previas del virus. Y aunque puede seguir mutando para volverse más infeccioso, no es probable que vuelva a duplicar su tasa de transmisión, afirmó el doctor Adam Lauring, experto en virus y enfermedades infecciosas de la Universidad de Michigan.
“Hemos visto una etapa de rápida evolución del virus. Ha estado cosechando la fruta madura, pero no hay una cantidad infinita de cosas que pueda hacer”, agregó Lauring.

Es posible que el virus se vuelva más letal, pero no hay un motivo evolutivo para que esto ocurra. También es improbable que las personas muy enfermas socialicen y transmitan el virus a otras personas.
Los expertos están observando si las variantes emergentes podrían ser más efectivas a la hora de evadir la protección que se desarrolla con la vacunación y el contagio. A medida que haya más gente vacunada, el virus tendría que poder propagarse entre personas con un cierto nivel de inmunidad para sobrevivir, apuntó el doctor Joshua Schiffer, virólogo del Centro de Investigación del Cáncer Fred Hutchinson.
“El virus podría adoptar una mutación que haga que la respuesta inmunitaria sea menos efectiva”, apuntó.
Si esto ocurre, los científicos pueden recomendar actualizar periódicamente las fórmulas de las vacunas, como ya ocurre con las de la gripe.